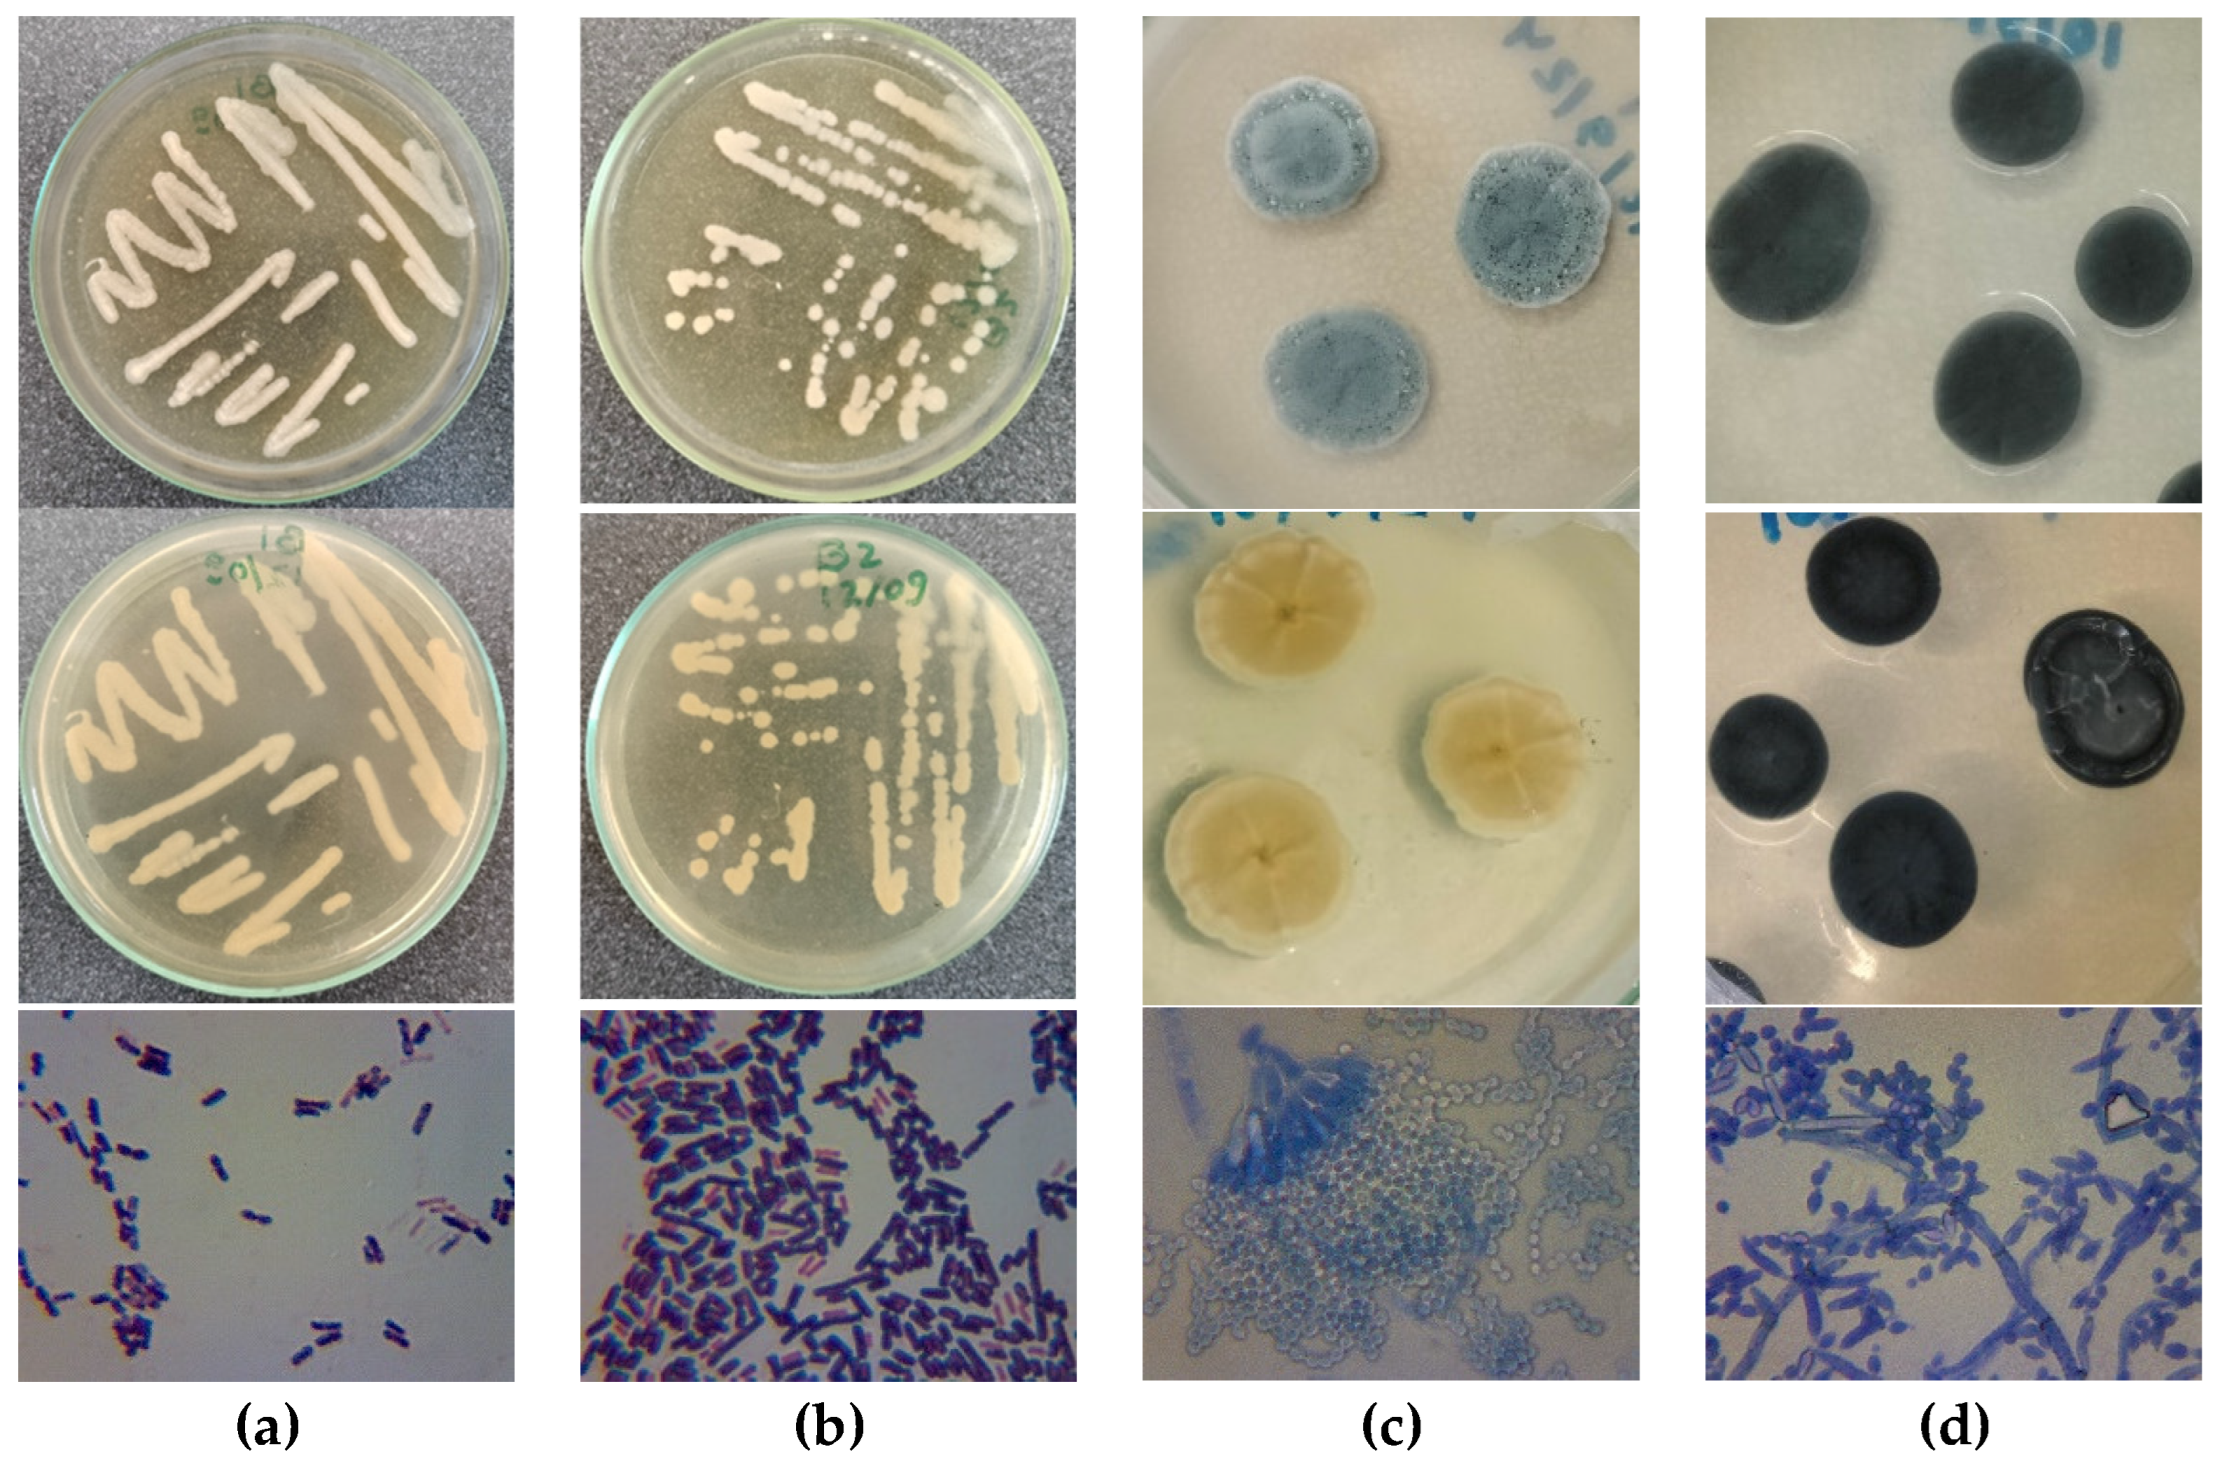
Preprints 140173 g004

1. Introduction
Biological agents such as fungi, bacteria, algae, and lichens play a significant role in the deterioration of built heritage [
1,
2,
3]. Most of the microbial genera found in these environments originate from natural air and soil microbiota, but some can be pathogenic to humans or cause opportunistic infections [
4,
5,
6,
7,
8]. Once these microorganisms colonize indoor and outdoor surfaces, they excrete biotic compounds, including organic and inorganic acids as well as enzymes, which dissolve minerals and degrade organic materials. This activity results in both structural and aesthetic damage to heritage surfaces [
5,
6,
9,
10,
11,
12,
13,
14].
Fungi, for instance, can penetrate stone and plaster with their hyphae. Many species also produce melanin pigments that darken facades and wall paintings, leaving them with a dirty appearance. Bacteria, on the other hand, excrete polymeric substances that enhance microbial adhesion and promote the formation of symbiotic biofilms. These biofilms not only protect microorganisms from ultraviolet radiation but also retain moisture, trap dirt, and accumulate organic molecules, contributing to surface blackening. This black discoloration is a common issue on historic buildings, statues, and artifacts worldwide, significantly diminishing their aesthetic value [
5,
7,
10,
11,
12,
14,
15,
16].
Cultural heritage conservation is a multidisciplinary field that aims to preserve art, architecture, and historical artifacts for future generations. Research has emphasized the importance of environmental control, such as regulating humidity and temperature, as well as the use of biocides and non-invasive cleaning methods to prevent microbial growth and preserve built heritage [
11,
16,
17,
18,
19].
Synthetic chemical biocides based on formaldehyde, phenols, and quaternary ammonium compounds have been commonly used to control microbial growth on built heritage. While effective, these substances pose significant risks. They are often toxic to humans and the environment, and their repeated application can lead to the development of resistant microbial strains [
4,
20]. Furthermore, synthetic biocides can have deleterious effects on the artworks themselves, causing discoloration or weakening of the materials. These issues have spurred interest in exploring more sustainable, less harmful alternatives for heritage conservation, such as natural biocides derived from essential oils and plant extracts [
4,
15,
21,
22,
23]. Essential oils extracted from aromatic plants are traditionally known for their antimicrobial, antifungal, and insecticidal properties with applications in other areas such as food preservation, cosmetics and pharmaceuticals [
22,
24,
25].
Essential oils are noted for presenting lower toxicity to humans and the environment compared to synthetic biocides [
4] and are generally considered more environmentally friendly than many synthetic compounds used in conservation and restoration. They are biodegradable and are not known to persist in the environment or accumulate in living organisms. Additionally, the natural origin of plant essential oils allows for sustainable production, as the plants are a renewable resource. This is particularly important as conservation and restoration practices increasingly adopt ecological engineering principles, aiming to reduce their environmental footprint in line with global sustainability goals. Essential oils can also be obtained by recycling vegetable residues from the aromatic plant supply chain [
26].
Despite the promising potential of essential oils as natural biocides, several challenges remain in their application to cultural heritage conservation. It is crucial to assess how these oils interact with the materials over time and whether repeated applications could result in unintended consequences, such as chemical degradation or discoloration [
20]. There is also a lack of research on application methods for essential oil-based biocides. Enhancing resource efficiency in conservation practices requires developing application methods that minimize material use and waste. Most existing studies focus on the use of direct contact methods, which may be unsuitable for delicate work such as paintings due to potential interference with pigments and substrates. Given that essential oils are volatile, this property could be leveraged to develop non-invasive biocidal atmospheres, a method particularly practical for smaller objects that can be placed in controlled atmosphere chambers or for fumigation treatments in indoor environments.
Regarding the use of essential oils as biocides in the preservation of mural paintings, significant challenges persist. Most research has concentrated on their application in conserving stone artworks and archival materials like paper, photographs, and graphic works. However, only 3.2% of studies have focused on mural paintings [
22], underscoring the need for further exploration in this area. This limited scope indicates a gap in resource efficiency and eco-efficiency within conservation practices, as the potential benefits of essential oils in mural conservation remain underexplored.
The conservation of mural paintings is often complicated by biological deterioration, and their integration into architectural structures, which exposes them directly to environmental conditions that favor microbial growth. Common microorganisms found on mural surfaces include fungi such as genera Aspergillus and Penicillium and bacteria like Bacillus species, all of which contribute to the deterioration of pigments and binding materials. These microorganisms produce acids and enzymes that degrade the organic components of the paintings, leading to discoloration, cracking, and flaking of the surface. Addressing these challenges is essential for the sustainability of cultural heritage preservation. As these biodeteriorative agents are persistent and difficult to completely eradicate, continuous intervention is required to maintain the integrity of these cultural assets [
19].
This study aims to provide insights into the use of essential oils as natural biocides for the preservation of mural paintings. Essential oils, extracted from endemic aromatic Portuguese plants, and their mixtures, were evaluated for their antimicrobial properties, specifically targeting microorganisms isolated from the deteriorated murals of the House of Moscadim. In addition to assessing their effectiveness in inhibiting microbial growth, the research also explored the possibility of using these essential oils in non-invasive conservation techniques. By doing so, the study not only highlights the essential oils’ potential for reducing microbial deterioration but also examines their suitability for practical application in cultural heritage preservation, with a focus on minimal intervention and safeguarding the integrity of the original artworks. This approach enhances the relevance of essential oils as a solution for the ecological conservation of mural art, promoting sustainability in heritage preservation practices.
2. Materials and Methods
2.1. Site Description
The House of Moscadim, located on the main street of Vila of Chamusca in the Ribatejo region of Portugal, is an 18th-century manor house (
Figure 1). It is considered unique in the village and one of the most important in the region. The house is distinguished by its historical and cultural significance, particularly due to the notable collection of tiles found inside. Additionally, it is unique among the local residences for its Pillement-style mural paintings. The diverse decorative connection between fresco, dry mural paintings, and tiles with the hous
e’s structure reflects its well-preserved state and the trends of a residence that has been inhabited continuously from the 18th century to the present day.
Currently, the house is safeguarded by the company Patrimonium and has been the focus of a conservation and musealization project aimed at turning it into a public-access laboratory. These actions include cultural mediation, conservation research, musealization, and historical studies, involving a multidisciplinary team in collaboration with higher educational institutions such as the Polytechnic Institute of Tomar. The distinctive measures for preservation and musealization not only highlight the architectural and artistic uniqueness of the house but also enrich the understanding of local, national, and international history. In this context, the project aims to achieve the restoration and conservation of the House of Moscadim using an ecological engineering approach. One specific goal is to test natural biocides in this unique environment, particularly in the mural painting of a central room on the upper floor, known as the Pillement room.
The Pillement Room (
Figure 2) Is adorned with tiles up to a height of one meter and features dry painting achieved through oil paint applied over the tile composition. The painting, which has a monochromatic tone and a narrative style reminiscent of the artist Jean Pillement’s atelier, consists of five medallions framed with floral motifs, both worked in oil on a thin layer of pre-dried lime. This artwork has been restored, covered, and outlined with plastic paint.
Aesthetical and structural damages were observed on the wall near the windows, indicating that the structure suffered physical issues due to previous localized roof leaks, which caused cracks, fissures, and conditions conducive to the development of biofilms. Microorganism samples were collected from this area for laboratory testing (
Figure 2).
2.2. Microorganisms Isolation: Morphological Characterization and Molecular Identification
The collection of microorganisms was conducted in situ at the House of Moscadim using the swabbing technique [
27] (
Figure 2 c) and d)). Samples were taken from pigmented biofilms formed on the wall paintings near the windows of the Pillement room. The biological material was maintained at 4°C in a sterile Ringer solution until further use. Cultivable microorganisms were isolated by subculturing onto appropriate solid culture media and incubated in the dark for 3-7 days at 22 ± 1°C. Bacteria were isolated using Tryptic Soy Agar (TSA, HiMedia), while fungi were isolated using Potato Dextrose Agar (PDA, HiMedia) supplemented with chlortetracycline.
The morphological characteristics of each colony were observed, and their size, shape, surface gloss, edge morphology, and color were recorded. After Gram staining, the single-cell morphology of the bacteria was observed under a 1000x microscope (Olympus, CH30). Additionally, the fruiting bodies and conidia produced by the filamentous fungi cultures growing on the PDA plates were examined under 400x microscope (Olympus CH30).
To genetically identify the isolated bacterial and fungal species, a colony from each was selected from the culture medium, suspended in 10 µL of PBS (Phosphate Buffered Saline; 1X, pH 7.4), applied to an FTA card, and allowed to dry for 2 hours at room temperature. The samples prepared were then sent to the STAB VIDA genetics laboratory (
https://www.stabvida.com/) laboratory for identification, according to the following procedure. For fungi, DNA was purified from cell culture stored on the FTA card, followed by PCR amplification of the rDNA segment containing ITS and D1/D2 regions using ITS5/LR6 primers; amplified products were then subjected to Sanger sequencing (sense and antisense), aligned for consensus sequence generation, and BLASTed against the NCBI database. For bacteria, DNA was purified from cell culture stored on the FTA indicating card, followed by PCR amplification of the 16S rDNA gene segment containing variable regions V1 to V9; amplified products were then subjected to Sanger sequencing (sense and antisense), aligned for consensus sequence generation, and BLASTed against the NCBI database
2.3. Essential Oils Obtention and Stock Biocide Solutions Preparation
The essential oils (Eos) were obtained from D’Alenguadiana Company (Alentejo, Portugal). The Eos were extracted by hydrodistillation from the aerial parts of four aromatic plants: Thyme (Thymus mastichina L.), fennel (Foeniculum vulgare Mill.), pennyroyal (Mentha pulegium L.), and green lavender (Lavandula viridis L’Hér.). These plants are native to the Portuguese territory and are produced organically and hand-harvested, promoting sustainability and resource efficiency in their cultivation and processing. The oils were stored at room temperature and protected from light until use.
The Eos were previously characterized by Gas Chromatography-Mass Spectrometry (GC-MS) using an Agilent 7890 GC coupled with an Agilent 5975 C inert XL mass selective detector (MSD) [
28]. The identification of EO components was carried out by comparing the mass spectra with those in the NIST and Wiley data system libraries. Retention indexes were calculated relative to C7–C25 n-alkanes and some components were also compared with pure standard compounds [
28].
Essential oil-based biocides, at a final concentration of 20% (v/v), were prepared by emulsifying the corresponding EO with an aqueous solution of SDS (sodium dodecyl sulfate, 1% m/v in deionized sterilized water). Additionally, a biocide containing a mixture of the four Eos, with each EO at a concentration of 5% for a total EO concentration of 20%, was also prepared.
2.3. Biocidal Potential Assessment
The biocidal potential of essential oil emulsions was evaluated using two methods, a direct contact method and a micro-atmosphere method. Both methods were used for the antifungal assays and only the contact method was used for the antibacterial assays.
The tests were conducted in Petri dishes (10 cm) with PDA culture medium for fungi and TSA medium for bacteria, some examples are shown in
Figure 3.
For the contact method, the disk diffusion test [
29] was employed. Microbial suspensions were prepared in sterilized water and 400 µL were spread onto the agar media. Then, 6 mm diameter sterilized filter paper discs (Macherey–Nagel) were placed onto the Petri dishes and imbibed with 12 µL of biocide. The samples were incubated in a thermostatic chamber at 22°C for four days, after which the radius of the zones of growth inhibition (inhibition halo, IH) was measured (
Figure 3 (a) and (b)).
In the second procedure, micro-atmosphere tests [
30,
31] were conducted. Mycelium plugs of filamentous fungi were inoculated on the agar media, and 40 µL of biocides and controls were applied to the lid of the inverted Petri plates. This method allowed the evaporation of volatile components without direct contact with the biological material. The plates were sealed with Parafilm
® M to create a modified micro-atmosphere. Samples were incubated in a thermostatic chamber at 22°C for seven days, and colony diameters were measured on days 3, 4, 5, and 7 (
Figure 3 © and (d)). The colony’s growth rate was calculated from the slope of the linear plot of colony diameter versus time.
As a positive control, a 1% v/v solution of the commercial biocide Biotin T® (CTS SRL) was used. Biotin T ® (BT) is a commercially available mixture with synergistic action of synthetic active ingredients, including n-octyl-isothiazolinone and a quaternary ammonium salt, designed to preserve, and repair surfaces from microbial attacks. For the negative control, a 1% solution of SDS in deionized sterile water was used to ensure that the solvent did not interfere with the activity of the Eos.
The tests were performed in triplicate, with ten random measurements of inhibition halo (IH) and colony diameter recorded for each test, resulting in a total of 30 measurements for each biocide-microorganism pair.
2.4. Statistical Analysis
The experimental data was organized and analyzed using Microsoft Excel® spreadsheet software, version 2206, 64-bit.
SPSS® software was employed to evaluate the biocidal effects of the Eos emulsions, namely, to calculate the means and the 95% confidence intervals of the colonies’ radius and the inhibition halos (IH). Analysis of Variance (ANOVA), and post hoc comparison tests with a confidence level of 95% (α = 0.05) were used, after checking normality using the Kolmogorov–Smirnov and Shapiro–Wilk tests. Tukey’s HSD post hoc method was applied to identify homogeneous subsets.
3. Results and Discussion
3.1. Microorganism Isolation and Identification
As previously mentioned, biological samples were collected from a wall near a window of Pillement room, an area that had experienced physical damage due to past roof infiltrations, which led to cracks and created conditions conducive to biofilm development, causing dark spots, as illustrated in
Figure 2.
The experimental approach led to the isolation and identification of four cultivable microorganisms: two bacterial species (B1 and B2) and two filamentous fungi (F1 and F2). The morphology of the colonies and cells for each species is shown in
Figure 4.
The Gram staining test revealed that both bacterial species are endospore-forming, Gram-positive bacillus. The B1 colonies are medium to large, reaching several millimeters in diameter after 24 to 48 hours of incubation at 22°C. They are circular with wavy, slightly irregular edges, opaque, and cream-colored, with a smooth to slightly wrinkled surface. This morphology is consistent with the species Bacillus wiedmannii, which was confirmed through molecular analysis with an identified similarity of 100%. B2 colonies are medium-sized, reaching approximately 2–5 mm in diameter after 24–48 hours of incubation at 22°C. They are circular with smooth, well-defined edges and exhibit an opaque, white to off-white color. The colony surface is smooth and has a slightly glossy appearance. This morphology is consistent with the species Bacillus mobilis, which was confirmed through molecular analysis with an identify similarity of 99.92%.
The F1 colonies were consistent with the genus Penicillium, exhibiting moderate to rapid growth on PDA at 22°C, have radial striae, and have a velvety to downy texture. The colonies are initially white and over time become bluish green, with a white border. The reverse of the plaque is pale yellowish with a lighter border. Microscopic examination of F1 is also compatible with Penicillium sp. with conidia on conidiophores. The conidia are arranged in long chains of globose shapes. This fungus was identified by molecular analysis as Penicillium brevicompactum (identity similarity 99.92%)
Colonies of F2 are consistent with the genus Cladosporium, showing moderate growth. The colonies range from olive-green to blackish as they mature, with a velvety texture. The surface appears slightly raised and uneven, and the margins are well-defined. The reverse side of the colonies displays a dark brown to black coloration. Microscopic observation of F2 revealed branched, erect conidiophores that produce chains of small, oval conidia. This fungus was identified by molecular analysis as Cladosporium cladosporioides (identity similarity 99 %).
Considering the specific context from where the fungi were isolated and considering the information provided by Trovão and Portugal (2021), these species might display the ensuing putative biodeterioration abilities:
P. brevicompactum – mineralization, fibrinolytic, proteolytic and cellulolytic;
C. cladosporioides – mineralization, ligninolytic, keratinolytic, lipolytic, proteolytic and cellulolytic. These genera are known for colonizing various substrates, including stone, plaster and wood, especially in environments with high humidity, such as walls damaged by water infiltration and poor ventilation. These fungi are associated with the production of secondary metabolites, that can cause discoloration and further material weakening, leading to both aesthetic and structural damage [
5,
7,
12,
15,
32,
33,
34]. Cladosporium species produce dark pigments that stain surfaces, while their hyphal growth can cause mechanical damage by penetrating building materials. Additionally, their metabolic activity leads to the production of organic acids that contribute to the chemical degradation of materials like limestone and gypsum. Penicillium species, on the other hand, can produce both enzymes and organic acids that accelerate the degradation of organic substrates like wood, textiles, and paper, as well as inorganic materials.
Concerning the isolated bacteria, bacillus species pose a significant threat to cultural heritage due to their ability to excrete enzymes and acid byproducts, that impact both organic and inorganic materials like paper, leather, coatings, stone and metal [
35,
36,
37]. The Gram-positive, endospore-forming Bacillus species can endure extreme conditions, allowing them to survive much longer than vegetative cells. This spore-forming capability provides Bacillus bacteria with high resistance to harsh environments.
Bacillus wiedmannii, for instance, has been identified within bacterial communities that form bioweathering crusts on limestone sculptures, contributing to their gradual deterioration [
37]. The
Bacillus mobilis species has also been recognized for its role in marble biodeterioration, by precipitating and metabolizing calcium carbonate, which can lead to damage in marble sculptures [
38].
3.2. Biocidal Potential Assessment
3.2.2. Antifungal Activity Assessed by Micro-Atmosphere Method
The antifungal efficacy of essential oils was assessed against P. brevicompactum and C. cladosporioides using the micro-atmosphere method. This method allows for the evaluation of volatile compounds’ ability to inhibit fungal growth without direct contact, enhancing eco-efficiency by minimizing material use and waste. This approach is particularly relevant in the context of heritage conservation, where non-invasive techniques are critical to preserving fragile surfaces.
Figure 5 shows the growth of
Penicillium brevicompactum and
Cladosporium cladosporioides colonies over time in response to the different essential oil-based emulsions. The graphs present the mean colony radius measured at 3, 4, 5, and 7 days.
Table 1 presents the initial colony radius (measured at 3 days and the colony growth rate G.R.) for each biocide and controls.
The results obtained reveal substantial differences in the antifungal performance of the various biocides. This variability is also reported in the literature and can be partly attributed to differences in the composition of essential oils [
4,
15,
39,
40]. In general, the major constituent confers the biological activity of the essential oil, although this activity often results from a synergistic action between several minor constituents. Additionally, it is worth noting that the composition of essential oils from the same plant species often varies depending on the region, as well as environmental, cultivation, and harvesting conditions [
28,
41,
42,
43,
44,
45].
For P. brevicompactum, fennel EO demonstrated the most pronounced inhibitory effect, with an initial colony radius of 0.12 ± 0.03 cm after 3 days and a low growth rate of 0.031 cm/day. These findings suggest that fennel EO contains highly effective antifungal compounds that act rapidly to suppress fungal growth. Pennyroyal EO also exhibited significant inhibition, with an initial radius of 0.21 ± 0.04 cm and a growth rate of 0.088 cm/day, indicating its potential utility in similar applications.
Lavender EO, while associated with a larger initial colony radius (0.30 ± 0.03 cm), maintained a strong inhibitory effect over time, as evidenced by its growth rate of 0.096 cm/day. This raises an important consideration regarding the mode of action of lavender EO: despite its slower initial effect, its ability to inhibit fungal growth over a longer duration may be advantageous in scenarios requiring sustained antimicrobial activity. The EO mixture, which combines the properties of multiple oils, showed an initial radius of 0.20 ± 0.03 cm and a growth rate of 0.090 cm/day, suggesting that this formulation could serve as an effective broad-spectrum antifungal agent.
The performance of the SDS control, with a much larger initial radius of 0.45 ± 0.03 cm and a high growth rate of 0.150 cm/day, confirms that the antifungal activity observed with the EOs is not attributable to the solvent system. In comparison, the commercial biocide Biotin T® produced an initial radius of 0.32 ± 0.07 cm and a growth rate of 0.109 cm/day, indicating that fennel and pennyroyal EOs may offer comparable, if not superior, antifungal efficacy under similar conditions.
In the case of C. cladosporioides, fennel EO once again demonstrated the most significant inhibitory activity, with a small initial radius of 0.08 ± 0.02 cm and a growth rate of 0.017 cm/day. This consistency across different fungal species highlights fennel EO as a particularly potent antifungal agent with broad-spectrum potential. Pennyroyal EO also exhibited effective inhibition, with an initial radius of 0.14 ± 0.03 cm and a growth rate of 0.034 cm/day, further supporting its role as a viable natural biocide.
Lavender EO demonstrated an initial radius of 0.21 ± 0.02 cm and a growth rate of 0.053 cm/day, similar to its performance against Penicillium. The EO mixture, with an initial radius of 0.19 ± 0.02 cm and a growth rate of 0.058 cm/day, reinforces the potential of EO combinations to provide effective control over diverse fungal species, potentially increasing the breadth of antifungal activity.
The SDS control, which exhibited the highest initial radius of 0.50 ± 0.02 cm and a growth rate of 0.139 cm/day, further confirmed that the antifungal effects observed are attributable to the essential oils themselves. The commercial biocide Biotin T® (initial radius of 0.33 ± 0.02 cm and growth rate of 0.115 cm/day) also performed as expected, yet the comparable efficacy of natural EOs, particularly fennel EO, suggests that these natural alternatives could effectively replace or complement synthetic biocides in certain contexts.
These results indicate that fennel EO consistently exhibited the strongest antifungal activity across both fungal species, characterized by rapid suppression of growth and sustained inhibition. Pennyroyal and lavender EOs also demonstrated considerable efficacy. The EO mixture, combining the properties of multiple oils, presents a promising broad-spectrum alternative to both individual EOs and synthetic biocides. Taken together, these findings highlight the potential for essential oils to serve as sustainable, environmentally friendly alternatives to traditional biocides in the conservation of heritage materials, offering effective microbial control while minimizing potential harm to delicate surfaces.
3.2.2. Antimicrobial Activity Assed by Contact Method
The antimicrobial efficacy of the essential oil emulsions was evaluated against the two filamentous fungi P. brevicompactum and C. cladosporioides and the two bacterial strains B. wiedmannii and B. mobilis using the disk diffusion method. This method assesses the direct inhibitory effect of the EO based biocides.
Figure 6 illustrates the inhibition halos formed after 4 days of incubation at 22 °C for each microbial species in response to the different biocides.
Table 2 presents the mean inhibition halo radius along with their respective confidence intervals at significance level of α = 0.05.
Like the biocidal effect obtained by the micro-atmosphere method, the results observed by the contact method also reveal significant differences in the antimicrobial performance of the various essential oils and the commercial biocide.
Fennel EO demonstrated the most pronounced inhibitory effect against P. brevicompactum, with a mean inhibition radius halo of 2.83 ± 0.16 cm. Notably, in some instances, the inhibition halo produced by fennel EO extended to the edge of the Petri dish, exceeding the measurable area due to the proximity between the disk and the dish wall. This indicates that the actual inhibitory effect could be even greater than recorded. The EO mixture also showed substantial antifungal activity, producing an inhibition halo of of 2.81 ± 0.20 cm. The commercial biocide Biotin T® resulted in an inhibition halo of 2.23 ± 0.11 cm, slightly lower than that observed for fennel EO and the EO mixture. Pennyroyal EO exhibited moderate antifungal activity against P. brevicompactum, with an inhibition halo of 1.31 ± 0.13 cm. In contrast, lavender EO and thyme EO did not display detectable inhibition against P. brevicompactum, indicating limited efficacy against this fungal species.
Against C. cladosporioides, the EO mixture produced the largest inhibition halo of 3.16 ± 0.24 cm. Both fennel EO and pennyroyal EO exhibited strong inhibitory effects with inhibition halos of 3.00 ± 0.09 cm and 2.80 ± 0.05 cm, respectively. Similar to the observations with P. brevicompactum., the inhibition halos for fennel EO and pennyroyal EO occasionally extended beyond the measurable area due to reaching the edge of the Petri dish. This suggests an even greater antifungal potency against C. cladosporioides. The commercial biocide Biotin T® generated an inhibition halo of 2.92 ± 0.04 cm, comparable to the efficacy of fennel EO. Thyme EO showed a smaller inhibition halo of 1.51 ± 0.11 cm, while lavender EO did not exhibit detectable inhibition against this fungus.
Regarding the bacterial strains, Biotin T® exhibited the largest inhibition halos, measuring 2.01 ± 0.15 cm for B. wiedmannii and 1.53 ± 0.06 cm for B. mobilis, confirming its established efficacy as a synthetic biocide. Fennel EO showed good antibacterial activity against B. wiedmannii, with an inhibition halo of 1.74 ± 0.23 cm, and moderate activity against B. mobilis, with a halo of 1.41 ± 0.20 cm. Lavender EO demonstrated antibacterial activity against B. wiedmannii, with an inhibition halo of 1.49 ± 0.23 cm, but was less effective against B. mobilis, producing a smaller halo of 0.83 ± 0.06 cm. Pennyroyal EO exhibited lower antibacterial activity, with inhibition halos of 0.82 ± 0.11 cm against B. wiedmannii and 0.51 ± 0.05 cm against B. mobilis. Thyme EO showed similar low activity, with inhibition halos of 0.83 ± 0.11 cm against B1 and 0.68 ± 0.08 cm against B. mobilis. The EO mixture demonstrated moderate antibacterial activity, with inhibition halos of 0.96 ± 0.11 cm for B. wiedmannii and 0.77 ± 0.03 cm for B. mobilis.
The negative control, consisting of a SDS solution, did not exhibit any inhibitory effect against any of the tested microorganisms. The inhibition halo radius was always less than that of the disk itself (0.3 cm), indicating no measurable antimicrobial activity. This confirms that the observed inhibition zones for the EOs and Biotin T® are attributable to their inherent antimicrobial properties rather than the solvent used in the emulsions.
5. Conclusions
This study provides substantial evidence that essential oils derived from four endemic Portuguese aromatic plants—specifically fennel (Foeniculum vulgare Mill.), pennyroyal (Mentha pulegium L.), lavender (Lavandula viridis L’Hér.), and thyme (Thymus mastichina L.)—possess significant antimicrobial properties against microorganisms responsible for the biodeterioration of mural paintings. By isolating two bacterial strains (Bacillus wiedmannii and Bacillus mobilis) and two fungal species (Penicillium brevicompactum and Cladosporium cladosporioides) from the deteriorated murals of the House of Moscadim, we were able to assess the efficacy of biocides based on these essential oils using both direct contact and micro-atmosphere methods.
Fennel essential oil based emerged as the most potent antifungal agent, exhibiting superior inhibitory effects against both fungal species when compared to the commercial synthetic biocide Biotin T®. Pennyroyal and lavender essential oils also demonstrated considerable inhibitory effects, though to a lesser extent than fennel oil. The essential oil mixture, which combined all four oils, showed potential synergistic effects, enhancing overall antimicrobial efficacy against the tested microorganisms.
The micro-atmosphere method proved to be an effective non-invasive approach for applying essential oil-based biocides. This method leverages the volatility of essential oils, allowing their antimicrobial compounds to act without direct contact with the mural surfaces. Such an approach is particularly advantageous for the conservation of delicate artworks, as it minimizes the risk of physical or chemical damage to the original materials. The ability of essential oils to inhibit microbial growth through volatilization opens new avenues for non-invasive conservation treatments, especially in enclosed or controlled environments.
These findings support the integration of essential oils into conservation practices as sustainable and environmentally friendly alternatives to synthetic biocides. Essential oils are biodegradable and have lower toxicity profiles, reducing environmental impact and health risks associated with synthetic chemical biocides. Implementing natural biocides aligns with ecological engineering principles and contributes to the sustainable preservation of cultural heritage, meeting global sustainability goals.
However, to fully harness the potential of essential oils in heritage conservation, further research is warranted. Long-term studies are needed to assess the effects of essential oils on various mural substrates and to monitor any potential chemical interactions or alterations over time. Optimizing application methods, such as determining the most effective concentrations, exposure times, and delivery systems, will enhance the practical applicability of these natural biocides. Additionally, exploring the efficacy of essential oil mixtures could lead to the development of broad-spectrum antimicrobial treatments, offering comprehensive protection against a wider range of biodeteriorative agents. Embracing principles of industrial symbiosis could also facilitate the integration of essential oil production with other industries, enhancing sustainability. The ecotoxicological potential of essential oils also needs to be evaluated.
Overall, this study contributes valuable insights into the application of essential oils as natural biocides for the conservation of mural paintings. The demonstrated efficacy of fennel, pennyroyal, and lavender essential oils provides a strong foundation for their integration into conservation strategies. Embracing these natural alternatives not only advances the field of cultural heritage preservation but also promotes environmental sustainability. By adopting essential oil-based biocides, conservators can protect invaluable artworks while minimizing ecological footprints and enhancing resource efficiency, ensuring that cultural treasures are preserved for future generations.
Author Contributions
Conceptualization, D.M. and F.C.; methodology, D.M., F.C. and L.M.; formal analysis, D.M. and V.J.; investigation, D.M., F.C. and L.M.; writing—original draft preparation, D.M., L.M. and V.J.; writing—review and editing, D.M., F.C. and V.J.; supervision, D.M. and F.C. All authors have read and agreed to the published version of the manuscript.
Funding
This research was partly funded by the Portuguese FOUNDATION FOR SCIENCE AND TECHNOLOGY, project UID/05488/2020 granted to Techn&Art.
Institutional Review Board Statement
Not applicable.
Data Availability Statement
The data used to support the findings of this study are available upon request.
Conflicts of Interest
The authors declare no conflicts of interest.
References
- Schröer, L.; Boon, N.; De Kock, T.; Cnudde, V. The Capabilities of Bacteria and Archaea to Alter Natural Building Stones – A Review. Int Biodeterior Biodegradation 2021, 165, 105329. [Google Scholar] [CrossRef]
- Sterflinger, K.; Pinzari, F. The Revenge of Time: Fungal Deterioration of Cultural Heritage with Particular Reference to Books, Paper and Parchment. Environ Microbiol 2012, 14, 559–566. [Google Scholar] [CrossRef] [PubMed]
- Crispim, C.A.; Gaylarde, C.C. Cyanobacteria and Biodeterioration of Cultural Heritage: A Review. Microb Ecol 2005, 49, 1–9. [Google Scholar] [CrossRef] [PubMed]
- Russo, R.; Palla, F. Plant Essential Oils as Biocides in Sustainable Strategies for the Conservation of Cultural Heritage. Sustainability 2023, 15, 8522. [Google Scholar] [CrossRef]
- Ahmed, E.A.-E.; Mohamed, R.M. Bacterial Deterioration in the Limestone Minaret of Prince Muhammad and Suggested Treatment Methods, Akhmim, Egypt. Geomaterials 2022, 12, 37–58. [Google Scholar] [CrossRef]
- Mateus, D.M.R.; Silva, R.B.; Costa, F.M.C.; Coroado, J.P.F. Microbiological Diversity in the Unfinished Sacristy Building of the Convent of Christ, Tomar, and Evaluation of Its Biocide-Based Control. Conservar Património 2013, 17, 11–20. [Google Scholar] [CrossRef]
- Carlo, E. Di; Chisesi, R.; Barresi, G.; Barbaro, S.; Lombardo, G.; Rotolo, V.; Sebastianelli, M.; Travagliato, G.; Palla, F. Fungi and Bacteria in Indoor Cultural Heritage Environments: Microbial-Related Risks for Artworks and Human Health. Environment and Ecology Research 2016, 4, 257–264. [Google Scholar] [CrossRef]
- Resende, M.A. de Biodeterioração de Monumentos Históricos. In Microbiologia ambiental; Azevedo, J.L. de, Melo, I.S. de, Eds.; Embrapa Meio Ambiente: Jaguariúna, SP, 2008; pp. 501–520.
- Văcar, C.L.; Mircea, C.; Pârvu, M.; Podar, D. Diversity and Metabolic Activity of Fungi Causing Biodeterioration of Canvas Paintings. Journal of Fungi 2022, 8, 589. [Google Scholar] [CrossRef]
- Baptista Neto, J.A.; Gaylarde, C.; Beech, I.; J. Smith, B.; J. McAlister, J. Degradação de Gnaisse e Granito Em Fachadas de Edifícios Históricos No Centro Do Rio de Janeiro. Sistemas & Gestão 2020, 15, 80–90. [CrossRef]
- Liu, X.; Koestler, R.J.; Warscheid, T.; Katayama, Y.; Gu, J.-D. Microbial Deterioration and Sustainable Conservation of Stone Monuments and Buildings. Nat Sustain 2020, 3, 991–1004. [Google Scholar] [CrossRef]
- Sterflinger, K.; Piñar, G. Microbial Deterioration of Cultural Heritage and Works of Art — Tilting at Windmills? Appl Microbiol Biotechnol 2013, 97, 9637–9646. [Google Scholar] [CrossRef] [PubMed]
- Shirakawa, M.A.; John, V.M.; Cincotto, M.Ai. Biodeterioração No Ambiente Construído. In Microbiologia Ambiental; Melo, I.S. de, Azevedo, J.L. de, Eds.; Embrapa Meio Ambiente: Jaguariúna, SP, 2008; pp. 478–499.
- Allsopp, D.; Seal, K.J.; Gaylarde, C.C. Introduction to Biodeterioration; Cambridge University Press, 2004; ISBN 9780521528870.
- Mateus, D.M.R.; Costa, F.M.C.; Triães, R.P. Essential Oils of Plants as Biocides Against Microorganisms Isolated from Portuguese Convent of Christ in Tomar. In; 2023; pp. 129–139.
- Cappitelli, F.; Abbruscato, P.; Foladori, P.; Zanardini, E.; Ranalli, G.; Principi, P.; Villa, F.; Polo, A.; Sorlini, C. Detection and Elimination of Cyanobacteria from Frescoes: The Case of the St. Brizio Chapel (Orvieto Cathedral, Italy). Microb Ecol 2009, 57, 633–639. [Google Scholar] [CrossRef] [PubMed]
- Palla, F.; Bruno, M.; Mercurio, F.; Tantillo, A.; Rotolo, V. Essential Oils as Natural Biocides in Conservation of Cultural Heritage. Molecules 2020, 25, 730. [Google Scholar] [CrossRef] [PubMed]
- Bhatnagar, P.; Khan, A.A.; Jain, S.K.; Rai, M.K. Biodeterioration of Archaeological Monuments and Approach for Restoration. In Geomicrobiology; Jain, S.K., Khan, A.A., Rai, M.K., Eds.; CRC Press Taylor and Francis Group Science Publishers: USA, 2010; pp. 255–302. [Google Scholar]
- Liu, X.; Qian, Y.; Wu, F.; Wang, Y.; Wang, W.; Gu, J.-D. Biofilms on Stone Monuments: Biodeterioration or Bioprotection? Trends Microbiol 2022, 30, 816–819. [Google Scholar] [CrossRef]
- Cappitelli, F.; Cattò, C.; Villa, F. The Control of Cultural Heritage Microbial Deterioration. Microorganisms 2020, 8, 1542. [Google Scholar] [CrossRef]
- Mateus, D.M.R.; Ferraz, E.; Perna, V.; Sales, P.; Hipólito-Correia, V. Essential Oils and Extracts of Plants as Biocides against Microorganisms Isolated from the Ruins of the Roman City of Conímbriga (Portugal). Environmental Science and Pollution Research 2024, 31, 40669–40677. [Google Scholar] [CrossRef]
- Reale, R.; Medeghini, L.; Botticelli, M. Stealing from Phytotherapy—Heritage Conservation with Essential Oils: A Review, from Remedy to Sustainable Restoration Product. Sustainability 2024, 16, 5110. [Google Scholar] [CrossRef]
- Casorri, L.; Masciarelli, E.; Ficociello, B.; Ietto, F.; Incoronato, F.; Di Luigi, M.; Pacioni, G. Natural Substances as Biocides in the Fungi Treatment on Artistic Products to Protect the Environment and Health of Restoration Workers. Ital J Mycol 2023, 52, 89–111. [Google Scholar]
- Angane, M.; Swift, S.; Huang, K.; Butts, C.A.; Quek, S.Y. Essential Oils and Their Major Components: An Updated Review on Antimicrobial Activities, Mechanism of Action and Their Potential Application in the Food Industry. Foods 2022, 11, 464. [Google Scholar] [CrossRef]
- Atanasov, A.G.; Waltenberger, B.; Pferschy-Wenzig, E.-M.; Linder, T.; Wawrosch, C.; Uhrin, P.; Temml, V.; Wang, L.; Schwaiger, S.; Heiss, E.H.; et al. Discovery and Resupply of Pharmacologically Active Plant-Derived Natural Products: A Review. Biotechnol Adv 2015, 33, 1582–1614. [Google Scholar] [CrossRef]
- Zaccardelli, M.; Roscigno, G.; Pane, C.; Celano, G.; Di Matteo, M.; Mainente, M.; Vuotto, A.; Mencherini, T.; Esposito, T.; Vitti, A.; et al. Essential Oils and Quality Composts Sourced by Recycling Vegetable Residues from the Aromatic Plant Supply Chain. Ind Crops Prod 2021, 162, 113255. [Google Scholar] [CrossRef]
- Verdier, T.; Coutand, M.; Bertron, A.; Roques, C. A Review of Indoor Microbial Growth across Building Materials and Sampling and Analysis Methods. Build Environ 2014, 80, 136–149. [Google Scholar] [CrossRef]
- Baptista, C.; Santos, L.; Emília Amaral, M.; Silva, L. Chemical Characterization of Essential Oils With a Biocide Base for Conservation and Restoration. KnE Materials Science 2022. [Google Scholar] [CrossRef]
- Balouiri, M.; Sadiki, M.; Ibnsouda, S.K. Methods for in Vitro Evaluating Antimicrobial Activity: A Review. J Pharm Anal 2016, 6, 71–79. [Google Scholar] [CrossRef]
- Stupar, M.; Grbić, M.Lj.; Džamić, A.; Unković, N.; Ristić, M.; Jelikić, A.; Vukojević, J. Antifungal Activity of Selected Essential Oils and Biocide Benzalkonium Chloride against the Fungi Isolated from Cultural Heritage Objects. South African Journal of Botany 2014, 93, 118–124. [Google Scholar] [CrossRef]
- Paolino, B.; Sorrentino, M.C.; Troisi, J.; Delli Carri, M.; Kiselev, P.; Raimondo, R.; Lahoz, E.; Pacifico, S. Lavandula Angustifolia Mill. for a Suitable Non-Invasive Treatment against Fungal Colonization on Organic-Media Cultural Heritage. Herit Sci 2024, 12, 53. [Google Scholar] [CrossRef]
- Trovão, J.; Portugal, A. Current Knowledge on the Fungal Degradation Abilities Profiled through Biodeteriorative Plate Essays. Applied Sciences 2021, 11, 4196. [Google Scholar] [CrossRef]
- Isola, D.; Bartoli, F.; Casanova Municchia, A.; Lee, H.J.; Jeong, S.H.; Chung, Y.J.; Caneva, G. Green Biocides for the Conservation of Hypogeal Mural Paintings Raised from Western and Eastern Traditions: Evaluation of Interference on Pigments and Substrata and Multifactor Parameters Affecting Their Activity. J Cult Herit 2023, 61, 116–126. [Google Scholar] [CrossRef]
- Mateus, D.M.R.; Ferraz, E.; Perna, V.; Sales, P.; Hipólito-Correia, V. Essential Oils and Extracts of Plants as Biocides against Microorganisms Isolated from the Ruins of the Roman City of Conímbriga (Portugal). Environmental Science and Pollution Research 2023, 31, 40669–40677. [Google Scholar] [CrossRef]
- Zerhouni, K.; Abbouni, B.; Kanoun, K.; Daouadji, K.L.; Tifrit, A.; Benahmed, M.; Chaouche, T.M. Isolation and Identification of Low Density Polythene-Degrading Bacteria from Soil of North West of Algeria. South Asian Journal of Experimental Biology 2019, 8, 76–82. [Google Scholar] [CrossRef]
- Ünlü-Yokuş, Y.; Göksay-Kadaifçiler, D.; Ilhan-Sungur, E. Amylolytic and Proteolytic Bacteria in Deteriorated Paper-Based Historical Manuscripts. J Sci Ind Res (India) 2024, 83. [Google Scholar] [CrossRef]
- Ma, C.; Fang, Z.; Li, X.; Liu, X. Identification of Bacterial Communities Involved in Bioweathering Crusts on Limestone Sculptures of the Longmen Grottoes. Coatings 2023, 13, 1506. [Google Scholar] [CrossRef]
- Nigro, L.; Mura, F.; Toti, M.P.; Cirigliano, A.; Rinaldi, T. Carbonatogenic Bacteria on the ‘Motya Charioteer’ Sculpture. J Cult Herit 2022, 57, 256–264. [Google Scholar] [CrossRef]
- Kalemba, D.; Kunicka, A. Antibacterial and Antifungal Properties of Essential Oils. Curr Med Chem 2003, 10, 813–829. [Google Scholar] [CrossRef]
- Piccaglia, R.; Marotti, M.; Giovanelli, E.; Deans, S.G.; Eaglesham, E. Antibacterial and Antioxidant Properties of Mediterranean Aromatic Plants. Ind Crops Prod 1993, 2, 47–50. [Google Scholar] [CrossRef]
- Mota, A.S.; Martins, M.R.; Arantes, S.; Lopes, V.R.; Bettencourt, E.; Pombal, S.; Gomes, A.C.; Silva, L.A. Antimicrobial Activity and Chemical Composition of the Essential Oils of Portuguese Foeniculum Vulgare Fruits. Nat Prod Commun 2015, 10. [Google Scholar] [CrossRef]
- Rodrigues, M.; Lopes, A.C.; Vaz, F.; Filipe, M.; Alves, G.; Ribeiro, M.P.; Coutinho, P.; Araujo, A.R.T.S. Thymus Mastichina: Composition and Biological Properties with a Focus on Antimicrobial Activity. Pharmaceuticals 2020, 13, 479. [Google Scholar] [CrossRef]
- Yasa, H.; Onar, H.Ç.; Yusufoglu, A.S. Chemical Composition of the Essential Oil of Mentha Pulegium L. from Bodrum, Turkey. Journal of Essential Oil Bearing Plants 2012, 15, 1040–1043. [Google Scholar] [CrossRef]
- Ouakouak, H.; Chohra, M.; Denane, M. Chemical Composition, Antioxidant Activities of the Essential Oil of <I>Mentha Pulegium</I> L, South East of Algeria. International Letters of Natural Sciences 2015, 39, 49–55. [Google Scholar] [CrossRef]
- Yamini, Y.; Sefidkon, F.; Pourmortazavi, S.M. Comparison of Essential Oil Composition of Iranian Fennel (Foeniculum Vulgare) Obtained by Supercritical Carbon Dioxide Extraction and Hydrodistillation Methods. Flavour Fragr J 2002, 17, 345–348. [Google Scholar] [CrossRef]
- Fidanza, M.R.; Caneva, G. Natural Biocides for the Conservation of Stone Cultural Heritage: A Review. J Cult Herit 2019, 38, 271–286. [Google Scholar] [CrossRef]
Figure 1.
House of Moscadim: (a) main I (b); Tile representation of a male “invitation” figure, a “muscadine” (a typical figure from the post-French Revolution era, distinguished by their elegant style of dress and the use of musk fragrance), origin of the current name of the house; (c) Dining room, highlighting the fresco painting above the tile composition.
Figure 1.
House of Moscadim: (a) main I (b); Tile representation of a male “invitation” figure, a “muscadine” (a typical figure from the post-French Revolution era, distinguished by their elegant style of dress and the use of musk fragrance), origin of the current name of the house; (c) Dining room, highlighting the fresco painting above the tile composition.
Figure 2.
Pillement room: (a) General view; (b) In situ test of biocides; (c) and (d) Sample collection for laboratory tests.
Figure 2.
Pillement room: (a) General view; (b) In situ test of biocides; (c) and (d) Sample collection for laboratory tests.
Figure 3.
Examples of inhibition halos using the disk diffusion contact method for Cladosporium cladosporioides: (a) Pennyroyal EO, and (b) positive control (BT, 1% v/v). Examples of micro-atmosphere tests for Penicillium brevicompactum: (c) mixture of essential oils, and (d) negative control (SDS, 1% w/v).
Figure 3.
Examples of inhibition halos using the disk diffusion contact method for Cladosporium cladosporioides: (a) Pennyroyal EO, and (b) positive control (BT, 1% v/v). Examples of micro-atmosphere tests for Penicillium brevicompactum: (c) mixture of essential oils, and (d) negative control (SDS, 1% w/v).
Figure 4.
Colony morphology (surface and reverse) and microstructure, after 7 days for fungi and 2 days for bacteria at 22 °C: (a) Bacillus wiedmannii; (b) Bacillus mobilis; (c) Penicillium brevicompactum; (d) Cladosporium cladosporioides.
Figure 4.
Colony morphology (surface and reverse) and microstructure, after 7 days for fungi and 2 days for bacteria at 22 °C: (a) Bacillus wiedmannii; (b) Bacillus mobilis; (c) Penicillium brevicompactum; (d) Cladosporium cladosporioides.
Figure 5.
Growth of Penicillium brevicompactum (a) and Cladosporium cladosporioides (b) colonies over time in response to different essential oil-based biocides. The graph presents the mean colony radius (cm) measured at 3, 4, 5, and 7 days, with confidence intervals at significance level α of 0.05 included for each measurement. The essential oils tested include fennel (Foeniculum vulgare), lavender (Lavandula viridis), pennyroyal (Mentha pulegium), thyme (Thymus mastichina), a mixture of essential oils, sodium dodecyl sulfate as a control, and the commercial biocide Biotin T®. Homogeneous subsets identified by Tukey’s B post hoc test are indicated for each treatment.
Figure 5.
Growth of Penicillium brevicompactum (a) and Cladosporium cladosporioides (b) colonies over time in response to different essential oil-based biocides. The graph presents the mean colony radius (cm) measured at 3, 4, 5, and 7 days, with confidence intervals at significance level α of 0.05 included for each measurement. The essential oils tested include fennel (Foeniculum vulgare), lavender (Lavandula viridis), pennyroyal (Mentha pulegium), thyme (Thymus mastichina), a mixture of essential oils, sodium dodecyl sulfate as a control, and the commercial biocide Biotin T®. Homogeneous subsets identified by Tukey’s B post hoc test are indicated for each treatment.
Figure 6.
Inhibition halos (radius, in cm) measured after 4 days of exposure to different essential oil-based biocides and the commercial biocide Biotin T® against the fungi Penicillium brevicompactum and Cladosporium cladosporioides, and the bacteria Bacillus wiedmannii and Bacillus mobilis. The essential oils tested include Foeniculum vulgare (fennel), Lavandula viridis (lavender), Mentha pulegium (pennyroyal), Thymus mastichina (thyme), and a mixture of these essential oils. Biotin T® served as the positive control. Letters above the bars indicate homogeneous subsets as determined by Tukey’s B post hoc test. “BDL” indicates inhibition below the detection limit. Error bars represent the confidence intervals at significance level α of 0.05 of the mean. An asterisk (*) above a bar indicates that the inhibition halo radius was larger than measured due to the distance between the disk and the Petri dish.
Figure 6.
Inhibition halos (radius, in cm) measured after 4 days of exposure to different essential oil-based biocides and the commercial biocide Biotin T® against the fungi Penicillium brevicompactum and Cladosporium cladosporioides, and the bacteria Bacillus wiedmannii and Bacillus mobilis. The essential oils tested include Foeniculum vulgare (fennel), Lavandula viridis (lavender), Mentha pulegium (pennyroyal), Thymus mastichina (thyme), and a mixture of these essential oils. Biotin T® served as the positive control. Letters above the bars indicate homogeneous subsets as determined by Tukey’s B post hoc test. “BDL” indicates inhibition below the detection limit. Error bars represent the confidence intervals at significance level α of 0.05 of the mean. An asterisk (*) above a bar indicates that the inhibition halo radius was larger than measured due to the distance between the disk and the Petri dish.
Table 1.
Antifungal activity of essential oil-based biocides against Penicillium brevicompactum and Cladosporium cladosporioides using the micro-atmosphere method. The table presents the initial colony radius (measured at 3 days, Radius ± confidence interval at significance level of α = 0.05), homogeneous subsets (HS) determined by Tukey’s B test, growth rate (G.R.) in cm/day, and the coefficient of determination (C.D.%) for each biocide. Lower growth rates and lower radius values indicate more effective inhibition of fungal growth.
Table 1.
Antifungal activity of essential oil-based biocides against Penicillium brevicompactum and Cladosporium cladosporioides using the micro-atmosphere method. The table presents the initial colony radius (measured at 3 days, Radius ± confidence interval at significance level of α = 0.05), homogeneous subsets (HS) determined by Tukey’s B test, growth rate (G.R.) in cm/day, and the coefficient of determination (C.D.%) for each biocide. Lower growth rates and lower radius values indicate more effective inhibition of fungal growth.
| Biocide |
Penicillium brevicompactum |
Cladosporium cladosporioides |
Radius ±
CI (cm) |
HS |
G.R
(cm/day) |
C.D. |
Radius ±
CI (cm) |
HS |
G.R
(cm/day) |
C.D. |
| Fennel |
0.12 ± 0.03 |
a |
0.031 |
0.92 |
0.08 ± 0.02 |
a, b |
0.017 |
0.86 |
| Lavender |
0.30 ± 0.03 |
d |
0.096 |
0.99 |
0.21 ± 0.02 |
d, e, f |
0.053 |
0.96 |
| Pennyroyal |
0.21 ± 0.04 |
a, b, c |
0.088 |
0.98 |
0.14 ± 0.03 |
b, c |
0.034 |
0.97 |
| Thyme |
0.24 ± 0.03 |
b, c, d |
0.101 |
0.98 |
0.29 ± 0.02 |
g, h, i |
0.091 |
0.99 |
| SDS |
0.45 ± 0.03 |
f |
0.15 |
0.97 |
0.50 ± 0.02 |
l, m |
0.139 |
0.99 |
| Mix |
0.20 ± 0.03 |
a, b, c |
0.09 |
0.93 |
0.19 ± 0.02 |
c, d, e |
0.058 |
0.97 |
| Biotin T®
|
0.32 ± 0.07 |
d, e |
0.109 |
0.99 |
0.33 ± 0.02 |
i, j |
0.115 |
1.00 |
Table 2.
Mean inhibition halos (cm) of essential oils and Biotin T® against the microorganisms isolated, with confidence intervals at significance level of α = 0.05. N.D. indicates no detectable inhibition (inhibition halo radius less than 0.3 cm). Confidence intervals are provided after the ‘±’ symbol.
Table 2.
Mean inhibition halos (cm) of essential oils and Biotin T® against the microorganisms isolated, with confidence intervals at significance level of α = 0.05. N.D. indicates no detectable inhibition (inhibition halo radius less than 0.3 cm). Confidence intervals are provided after the ‘±’ symbol.
| Biocide |
Penicillium
brevicompactum
|
Cladosporium
Cladosporioides
|
Bacillus
wiedmannii
|
Bacillus
mobilis
|
Radius ±
CI (cm)
|
HS |
Radius ±
CI (cm)
|
HS |
Radius ±
CI (cm)
|
HS |
Radius ±
CI (cm)
|
HS |
| Fennel |
2.83 ± 0.16* |
c |
3.00 ± 0.09* |
b, c |
1.74 ± 0.23 |
b,c |
1.41 ± 0.20 |
c |
| Lavender |
N.D. |
- |
N.D. |
- |
1.49 ± 0.23 |
b |
0.83 ± 0.06 |
b |
| Pennyroyal |
1.31 ± 0.13 |
a |
2.80 ± 0.05* |
b |
0.82 ± 0.11 |
a |
0.51 ± 0.05 |
a |
| Thyme |
N.D. |
- |
1.51 ± 0.11 |
a |
0.83 ± 0.11 |
a |
0.68 ± 0.08 |
a, b |
| Mixture |
2.81 ± 0.20 |
c |
3.16 ± 0.24 |
c |
0.96 ± 0.11 |
a |
0.77 ± 0.03 |
b |
| Biotin T®
|
2.23 ± 0.11 |
b |
2.92 ± 0.04 |
b,c |
2.01 ± 0.15 |
c |
1.53 ± 0.06 |
c |
|
Disclaimer/Publisher’s Note: The statements, opinions and data contained in all publications are solely those of the individual author(s) and contributor(s) and not of MDPI and/or the editor(s). MDPI and/or the editor(s) disclaim responsibility for any injury to people or property resulting from any ideas, methods, instructions or products referred to in the content. |
© 2024 by the authors. Licensee MDPI, Basel, Switzerland. This article is an open access article distributed under the terms and conditions of the Creative Commons Attribution (CC BY) license (http://creativecommons.org/licenses/by/4.0/).